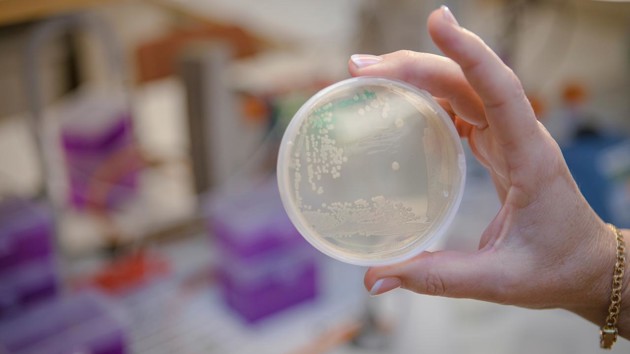

MIMS Spotlight Series: Louise meets Monique Johnson
Louise Lindbäck had a chat with Monique Johnson, a postdoctoral fellow in the lab of MIMS Group Leader Ellen Bushell, studying malaria-parasite host interactions.
Published: 2025-09-24 Updated: 2025-12-05, 11:07 Text: Nora Lehotai

Monique Johnson på labb 2025
ImageMariko DaleMeet Monique Johnson
As a postdoctoral fellow at MIMS, she explores the complex biology of malaria parasites, developing innovative genetic tools to uncover new drug targets. With a background that spans from Cambridge to Umeå, her work connects molecular detail with large-scale screening. Outside the lab, she embraces Sweden’s nature while still dreaming of diving adventures in the sea. Let’s meet Monique!
Can you tell us about your role at MIMS and what you are currently working on?
"I am a postdoctoral research fellow in Ellen Bushell’s lab at the Department of Molecular Biology, Umeå University. I am working on exported proteins in the rodent model malaria parasite Plasmodium berghei, as an in vivo model for human-infecting parasite Plasmodium falciparum. The Bushell lab develops genetic tools to investigate P. berghei gene function at a genome-scale, and we are particularly interested in those parasite genes that drive critical host-parasite interactions that shape infection and disease. The lab has recently established a CRISPR-Cas9 system that enables largescale gene knockout screens, dubbed PbHiT.
I am continuing work on the PbHiT system, adapting it to study essential genes using conditional knockdown approaches. Along with other members of the lab, I am developing two different systems that are tailored to either exported or non-exported proteins and that both facilitate conditional mis-localisation of the target protein. This allows us to study essential parasite genes for which viable knockout mutants cannot be obtained. We are also exploring the roles in virulence and sequestration of a set of genes that upon knockout gives rise to slow growth in vivo, which is uniquely possible in the in vivo model P. berghei provides."
What impact do you hope your research will have on your field and beyond?
"I hope that with this project we can provide the tools to identify a greater number of drug targets in malaria, while also exploring some of these targets ourselves from these screens to increase the opportunities for identifying disease-reducing drugs."
What were you doing before you joined MIMS, and what attracted you to start a position here?
"Before I joined MIMS I was researching for my PhD at the University of Cambridge with Professor Catherine Merrick. During my PhD, I was working on cell cycle checkpoints in the human-infective malaria parasite P. falciparum and another related parasite, Toxoplasma gondii. I used cell-based assays, protein expression, immunofluorescence and replication tracking to investigate the potential presence of cell cycle checkpoints and response to DNA damage. I found these pathogenic parasites and the holes in understanding their fundamental divergent eukaryotic biology particularly intriguing.
I saw through an email forwarded to my supervisor that Ellen was looking for a Postdoc and I was inspired by the Bushell lab’s novel approaches to investigate multiple candidates at once in larger scale screens, not yet possible in P. falciparum. I thought the project outlined seemed something I could bring my background in molecular biology and understanding of malaria parasites to. I also want to learn more about larger scale genetic screens and how to use an in vivo model to understand malaria infections through host-parasite interactions."
What motivated you to become a postdoc researcher?
"I thoroughly enjoyed and felt motivated in my research throughout my master’s and PhD projects. Plasmodium parasites are uniquely interesting in the challenges they present to gain understanding, their intriguing biology and the problems with current disease treatments. I wanted to further explore infection biology in this organism in a more high-throughput way and investigate host-parasite interactions (which is a particularly intriguing area of Plasmodium biology). This postdoc felt natural to explore these organisms further in a scalable meaningful way, along with the adventure of moving to Sweden for the first time."
What do you enjoy most about working at Umeå University?
"The friendly environment, the supportive nature of the postdoc community and the interesting science happening within the department and in the rest of Umeå University that we hear about often in seminars."
If you were not in your current profession, what do you think you would be doing?
"I might be underwater photographer or scuba diving instructor in a tropical location; I love to scuba dive and explore the oceans."
Two things on my bucket list: Go Skydiving. Travel around Vietnam experiencing the culture and nature of the country.
Preferred way to relax: Going for walks, exploring nature and anywhere with rivers, lakes or the seaside.
Favourite sport or activity: "I have been really enjoying learning some new winter sports while in Umeå such as cross-country skiing."
Infection Biology
Umeå University is at the international forefront in the research area of infection biology.

Department of Molecular Biology
The Department is affiliated to both the Faculty of Science and Technology and to the Faculty of Medicine.

Ellen Bushell lab
The group studies parasite-host interactions that govern malaria infection and disease.







